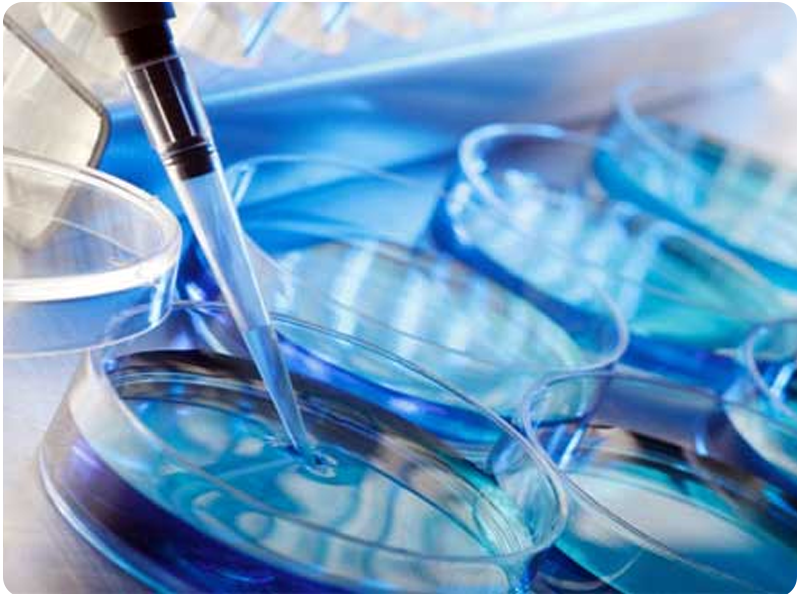
...

A) Quirúrgica: Es un procedimiento que se realiza posterior a la atención de un parto, durante la cesárea o de manera electiva como método definitivo por vía laparoscópica o cirugía abierta.
B) Existe también la Oclusión Tubaria Bilateral, o trompas obstruidas, o trompas tapadas secundarias a alguna enfermedad como Endometriosis, infecciones, o alguna cirugía pélvica.



A pesar de tener las trompas obstruidas por enfermedad o por cirugía existe la posibilidad de lograr un embarazo.
Para lograr un embarazo posterior a una oclusión tubaria bilateral existen dos opciones:
1. La cirugía para volver a hacer permeables las trompas o recanalización tubaria. Esta técnica actualmente resulta obsoleta, ya que es invasiva, y la tasa de éxito es muy baja.
2. Tratamiento de Reproducción Asistida de Alta Complejidad como la Fertilización in vitro (Fecundación in Vitro, FIV): es la mejor alternativa para lograr el embarazo tras la Oclusión Tubaria Bilateral.
Es no invasivo y la posibilidad de éxito es mayor: Consiste en la extracción de los óvulos y fecundación de los mismos en un laboratorio de manera que se hace una selección de los mejores embriones para posterior ser colocados dentro del útero de la mujer, por lo tanto las trompas de
Falopio ya no son indispensables. Dentro de las ventajas del FIV evitamos las posibles complicaciones de la cirugía, un embarazo ectópico, se logra el embarazo en poco tiempo, por lo que es la mejor opción de tratamiento con una alta tasa de éxito es la Fertilización in vitro (FIV). En Fertygen, encontramos que los casos de Obstrucción Tubaria Bilateral en los que hacemos un Tratamiento de Reproducción Asistida de Alta Complejidad tienen una alta tasa de éxito. Te esperamos.